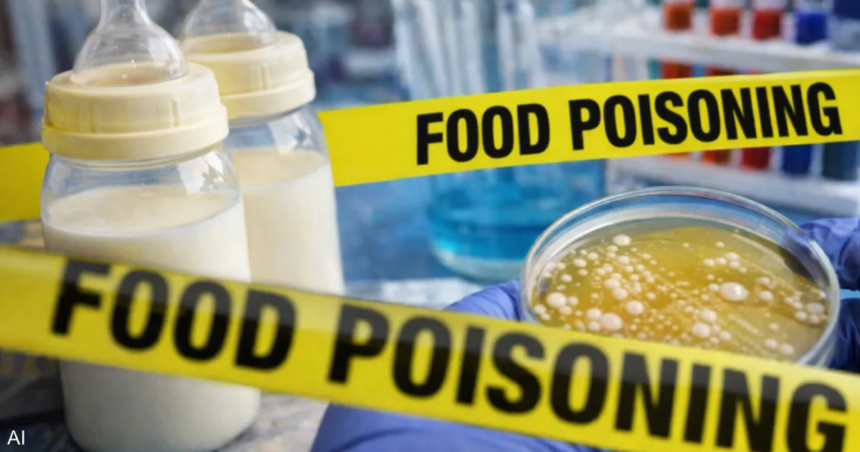

وقال المسؤولون إن الاختبارات التي أجرتها إدارة الغذاء والدواء الأميركية وجدت نوعا من البكتيريا الذي يمكن أن يسبب المرض في عينتين مرتبطتين بحليب الأطفال.
ووجدت الإدارة أن البكتيريا الموجودة في علبة حليب غير مفتوحة تتطابق مع عينة من طفل مريض، كما أنها تتطابق مع التلوث المكتشف في عينات من مسحوق الحليب العضوي الكامل الدسم المستخدم في صنع حليب الأطفال في “باي هارت” والتي تم جمعها واختبارها من قبل الشركة.
كما وجدت اختبارات إدارة الغذاء والدواء تلوثا في عينة من الحليب المجفف كامل الدسم المقدم لشركة “باي هارت”، وقد تطابقت مع الجرثومة الموجودة في عينة نهائية من حليب الشركة.
وقالت الإدارة في بيان إن النتائج ليست قاطعة وإن التحقيق مستمر “لتحديد مصدر التلوث”.